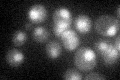
YCL016C
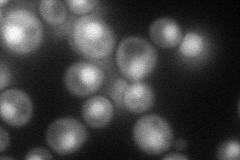
YCL016C
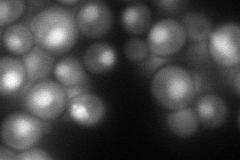
YCL016C
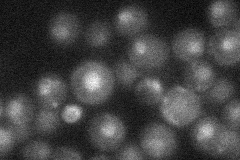
YCL016C
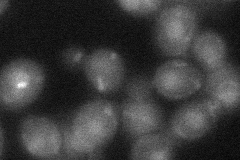
YCL016C

View description
Subunit of a complex with Ctf8p and Ctf18p that shares some components with Replication Factor C, required for sister chromatid cohesion and telomere length maintenance
Localization:
Intensity:
Fold change:
Significance:
-
C’ GFP library in SD
nucleus21.19 -
N' NOP1pr-GFP in SD
cytosol,nucleus74.664 -
N' TEF2pr-mCherry in SD
nucleus86.4073 -
N' NATIVEpr-GFP in SD
nucleus22.7167 -
N' TEF2pr-VC and Cyto-VN in SD
nucleus31.0519 -
C’ GFP library in SD+DTT

nucleus24.211.14No -
C’ GFP library in SD+H2O2

nucleus24.111.13No -
C’ GFP library in Starvation Media

nucleus32.381.52Yes -
C’ GFP library on the background of Pup2-DaMP

nucleus -
C’ GFP library on the background of CCT mutant

nucleus26.66711.25818No
